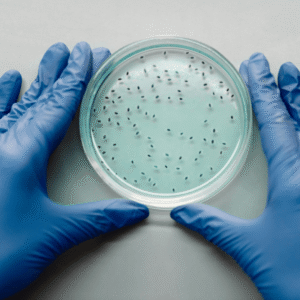
Can-Bacteria-Really-Grow-on-Nitrile-Gloves?

Do Biodegradable Gloves Meet OSHA and ISO Standards?
Biodegradable gloves are gaining attention as organizations work to cut waste without sacrificing safety. Their rapid breakdown in active landfill environments offers a meaningful step

Biodegradable gloves are gaining attention as organizations work to cut waste without sacrificing safety. Their rapid breakdown in active landfill environments offers a meaningful step

Vinyl gloves are common in food handling, light cleaning, and settings where short tasks require a quick, low-cost barrier. Many buyers choose them because they

Biodegradable nitrile gloves have gained attention as industries look for dependable protection with lower environmental impact. One common question follows quickly: if a glove is

Disposable gloves support food handling, healthcare tasks, laboratory work, and everyday hygiene routines. Yet their environmental footprint continues to spark questions. How long do they

Nitrile gloves are widely used across healthcare, manufacturing, food handling, and household activities. Their strength, resistance, and reliability make them a dependable choice in settings

Disposable gloves are used across healthcare, industry, food handling, and daily tasks. Their purpose is simple: provide a protective barrier. But different glove materials carry

Hospitals depend on gloves every single day. They are used in wards, operating rooms, diagnostic areas, and anywhere staff interact with patients or samples. This

Compostable and biodegradable products now appear in packaging, household goods, and workplace supplies. Both terms suggest a gentler impact on disposal systems, yet they do

Across industries, disposable gloves have become an indispensable component of daily operations. From healthcare to food processing, they protect users and maintain hygiene standards. Yet,
Nitrile gloves are trusted for their reliability, strength, and consistent protection. They are the standard choice across laboratories, hospitals, food industries, and domestic environments. Their

Disposable gloves have become a necessity in healthcare, food service, laboratories, and manufacturing. They protect workers from contaminants, maintain hygiene standards, and uphold safety protocols.

Biodegradable gloves are gaining attention as industries and individuals look for safer and more responsible ways to manage waste. They serve the same purpose as

Gloves have become everyday items in healthcare, laboratories, food handling, and even household tasks. They act as a barrier between the skin and potential contaminants.

Safe, Sustainable Protection for Those Who Need It Most At Earth Safe PPE, we know that those working in healthcare and care environments rely on

Food safety remains one of the most regulated aspects of production and handling. Every stage, from processing to packaging, must align with FDA requirements. Protective

As the hospitality industry evolves, sustainability is becoming a critical focus. With increasing awareness of environmental issues, hotels, restaurants, and catering services are searching for

Mastering EN 374 Understanding the EN 374 standard is crucial for selecting the right gloves to protect against hazardous chemicals and micro-organisms. At Earth Safe

Disposable gloves are used in countless settings, from healthcare and laboratories to food handling and home tasks. Their convenience and protection make them indispensable. Yet,

Nitrile gloves are a staple across healthcare, industrial, and domestic sectors. Their durability, resistance to chemicals, and reliable barrier protection make them a widely used

Nitrile gloves have become a staple across industries. From healthcare and laboratories to food handling and general household use, their strength and resistance make them